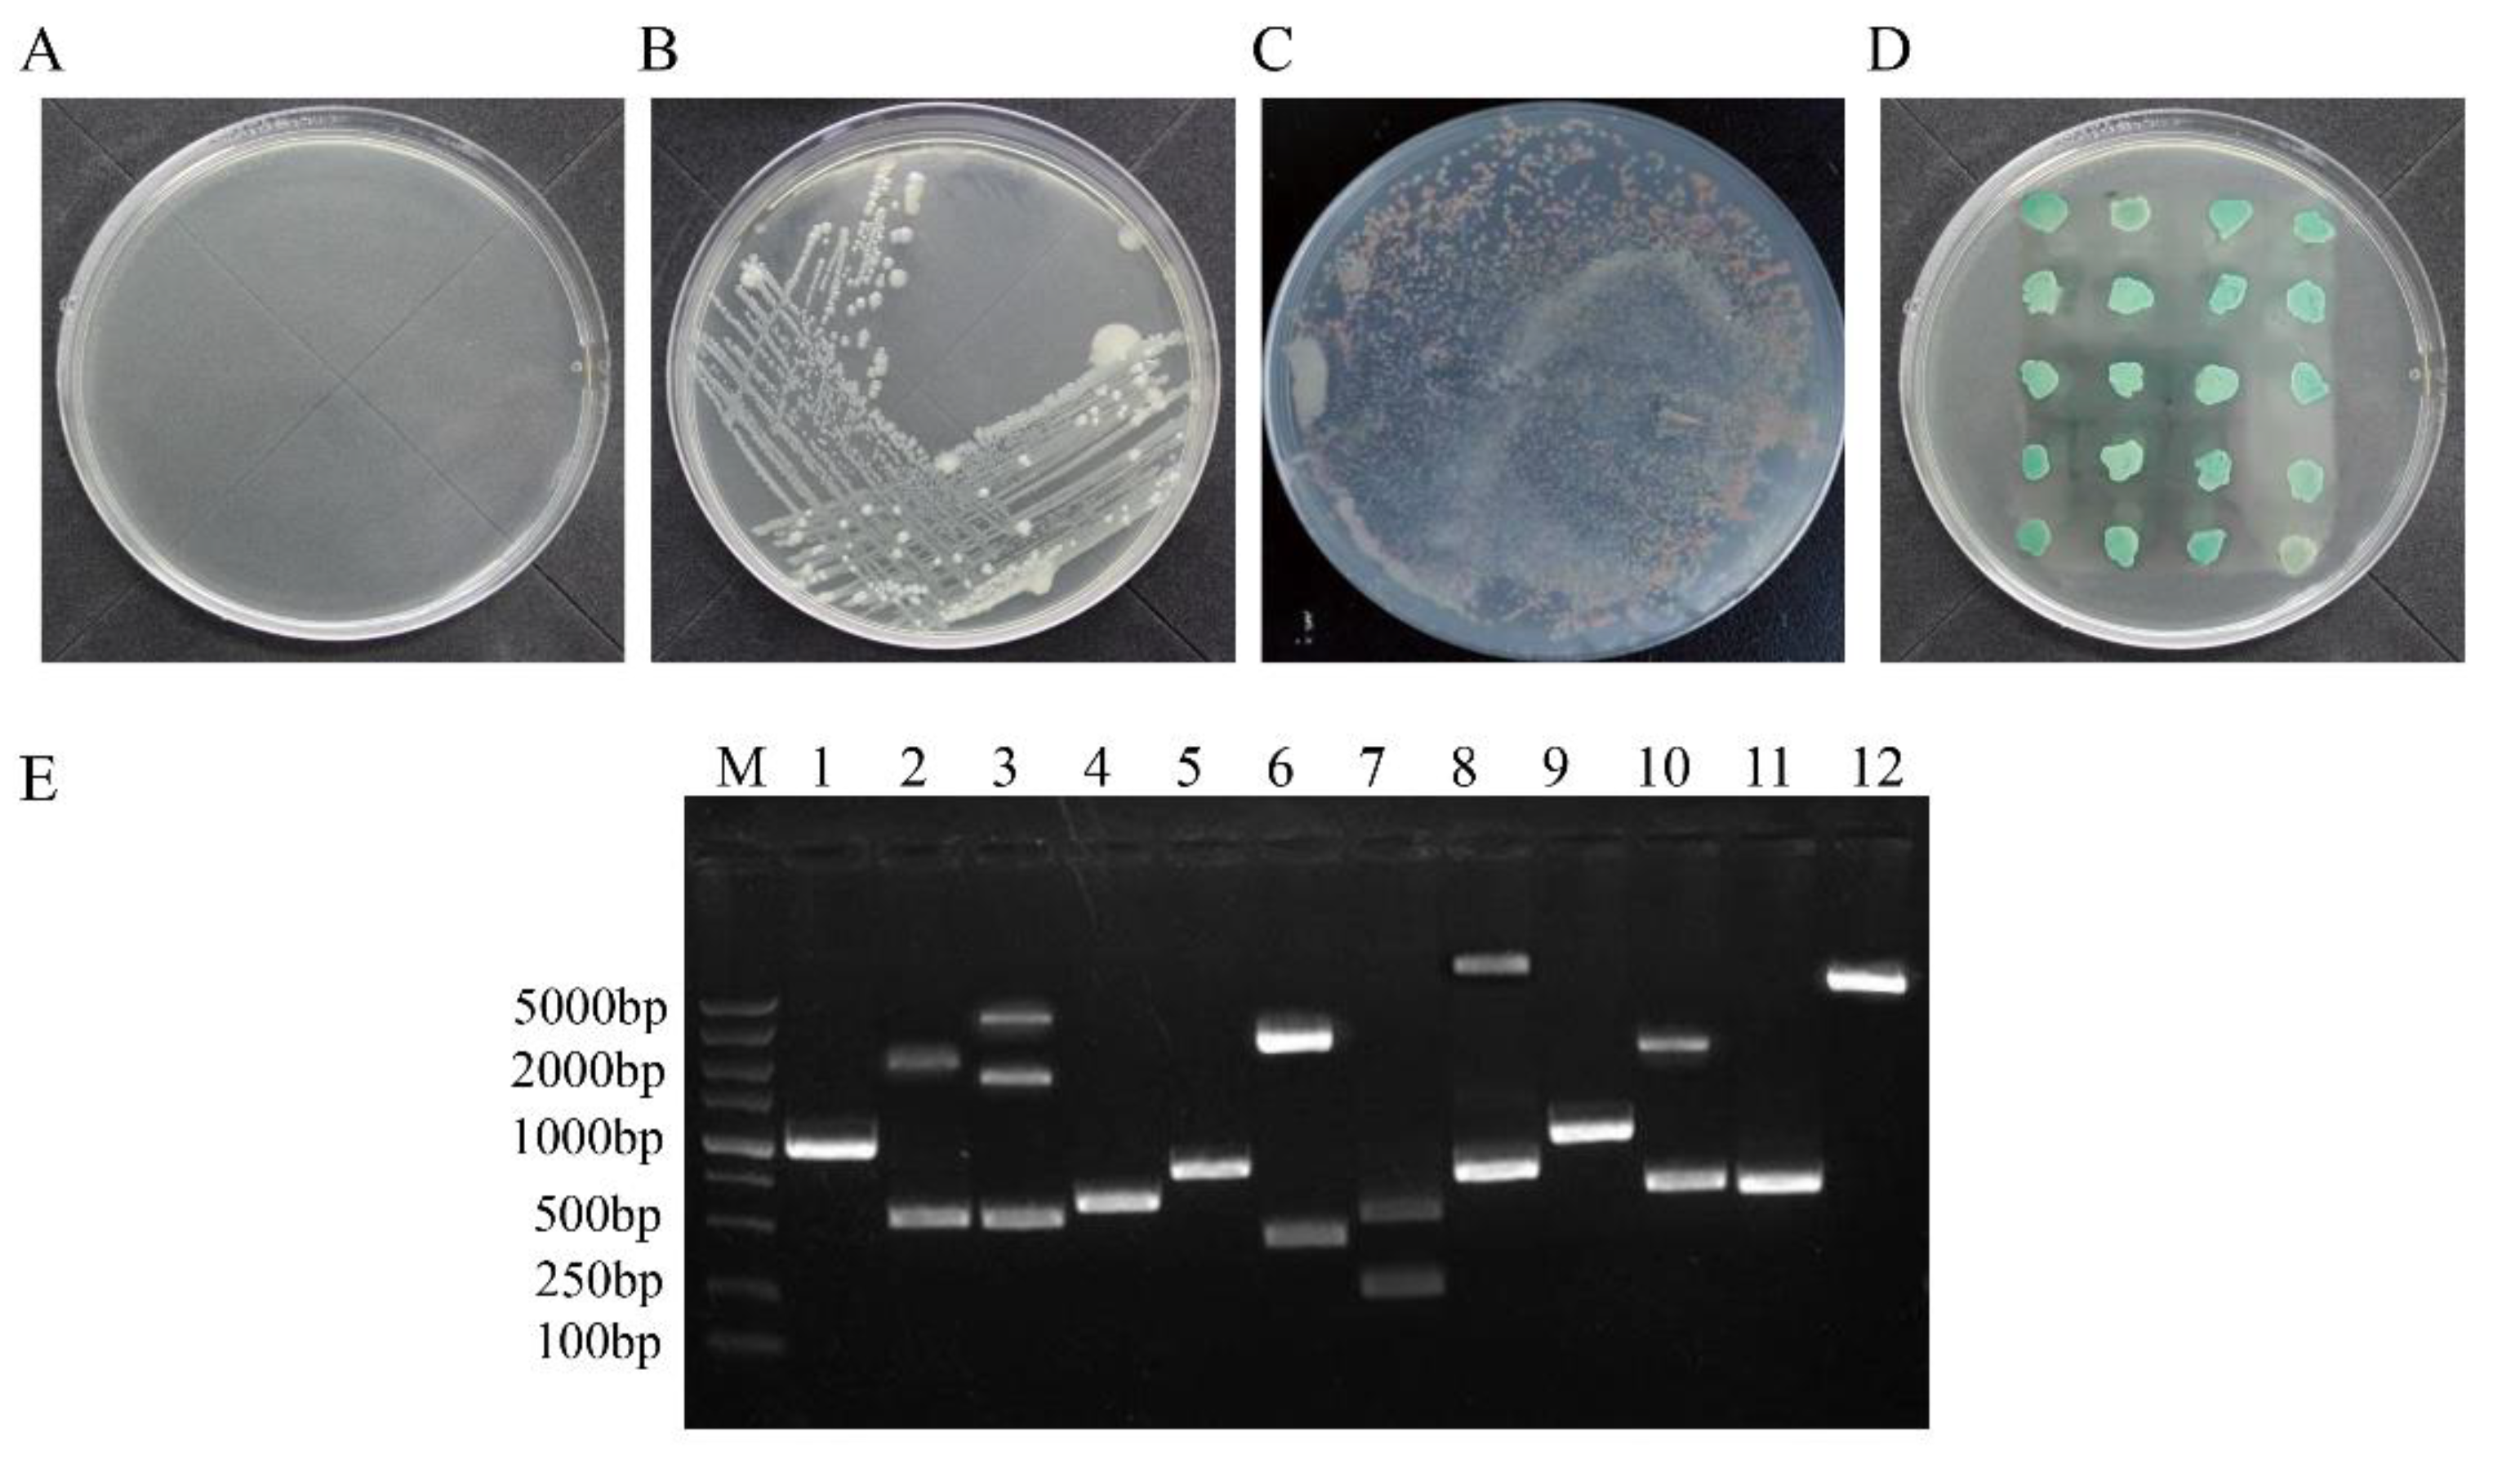
Viruses 14 00892 g001 Viruses 14 00892 g001

Identification and Functional Analyses of Host Proteins Interacting with the p17 Protein of Avian Reovirus
Abstract
1. Introduction
2. Materials and Methods
2.1. Cells and Virus
2.2. Reagents
2.3. Cell Culture and Transfection
2.4. Yeast Two-Hybrid Screen
2.5. Functional Classification and Pathway Analysis
2.6. Confocal Laser Scanning Microscopy Assay
2.7. Reciprocal Coimmunoprecipitation (co-IP) Assay
2.8. GST Pulldown Assays
2.9. Transfection with siRNA
2.10. Western Blot Assays
2.11. Quantitative RT-PCR (qRT-PCR)
2.12. Overexpression of Target Protein Mediated by Recombinant Plasmids
2.13. MTT Assay
2.14. Statistical Analysis
3. Results
3.1. Identification of Cellular Proteins That Interact with the ARV p17 Protein through Screening of a Chicken cDNA Library
3.2. Positive Protein Confirmation and Sequence Analysis
3.3. Functional Classification and Pathway Analysis
3.4. Construction of the ARV p17-Cellular Protein Interaction Network
3.5. ARV p17 Protein Colocalizes with PQBP1/IGF2BP1 in Host Cells
3.6. ARV p17 Protein Interacts with PQBP1/IGF2BP1 In Vivo and In Vitro
3.7. The mRNA Expression of Interacting Proteins after ARV Infection
3.8. The Selected Proteins Have Different Effects on Viral Replication
4. Discussion
Author Contributions
Funding
Institutional Review Board Statement
Data Availability Statement
Conflicts of Interest
References
- Lu, H.; Tang, Y.; Dunn, P.A.; Wallner-Pendleton, E.A.; Lin, L.; Knoll, E.A. Isolation and molecular characterization of newly emerging avian reovirus variants and novel strains in Pennsylvania, USA, 2011–2014. Sci. Rep. 2015, 5, 14727. [Google Scholar] [CrossRef] [PubMed]
- Zhang, C.; Hu, J.; Wang, X.; Wang, Y.; Guo, M.; Zhang, X.; Wu, Y. Avian reovirus infection activate the cellular unfold protein response and induced apoptosis via ATF6-dependent mechanism. Virus Res. 2021, 297, 198346. [Google Scholar] [CrossRef]
- Wang, S.; Xie, L.; Xie, Z.; Wan, L.; Huang, J.; Deng, X.; Xie, Z.Q.; Luo, S.; Zeng, T.; Zhang, Y.; et al. Dynamic Changes in the Expression of Interferon-Stimulated Genes in Joints of SPF Chickens Infected With Avian Reovirus. Front. Vet. Sci. 2021, 8, 618124. [Google Scholar] [CrossRef] [PubMed]
- Glass, S.E.; Naqi, S.A.; Hall, C.F.; Kerr, K.M. Isolation and characterization of a virus associated with arthritis of chickens. Avian Dis. 1973, 17, 415–424. [Google Scholar] [CrossRef]
- Spandidos, D.A.; Graham, A.F. Physical and chemical characterization of an avian reovirus. J. Virol. 1976, 19, 968–976. [Google Scholar] [CrossRef]
- Boehme, K.W.; Guglielmi, K.M.; Dermody, T.S. Reovirus nonstructural protein sigma1s is required for establishment of viremia and systemic dissemination. Proc. Natl. Acad. Sci. USA 2009, 106, 19986–19991. [Google Scholar] [CrossRef] [PubMed]
- Garzelli, C.; Onodera, T.; Ray, U.R.; Notkins, A.L. The S1 gene from reovirus type 1 is required for immunosuppression. J. Infect. Dis. 1985, 152, 640–643. [Google Scholar] [CrossRef] [PubMed]
- Bodelon, G.; Labrada, L.; Martinez-Costas, J.; Benavente, J. The avian reovirus genome segment S1 is a functionally tricistronic gene that expresses one structural and two nonstructural proteins in infected cells. Virology 2001, 290, 181–191. [Google Scholar] [CrossRef]
- Huang, W.R.; Li, J.Y.; Wu, Y.Y.; Liao, T.L.; Nielsen, B.L.; Liu, H.J. p17-modulated Hsp90/Cdc37 complex governs oncolytic avian reovirus replication by chaperoning p17 that promotes viral protein synthesis and accumulation of viral proteins sigmaC and sigmaA in viral factories. J. Virol. 2022, 96, e00074-22. [Google Scholar] [CrossRef] [PubMed]
- Costas, C.; Martinez-Costas, J.; Bodelon, G.; Benavente, J. The second open reading frame of the avian reovirus S1 gene encodes a transcription-dependent and CRM1-independent nucleocytoplasmic shuttling protein. J. Virol. 2005, 79, 2141–2150. [Google Scholar] [CrossRef][Green Version]
- Huang, W.R.; Chi, P.I.; Chiu, H.C.; Hsu, J.L.; Nielsen, B.L.; Liao, T.L.; Liu, H.J. Avian reovirus p17 and sigmaA act cooperatively to downregulate Akt by suppressing mTORC2 and CDK2/cyclin A2 and upregulating proteasome PSMB6. Sci. Rep. 2017, 7, 5226. [Google Scholar] [CrossRef]
- Liu, H.J.; Lin, P.Y.; Lee, J.W.; Hsu, H.Y.; Shih, W.L. Retardation of cell growth by avian reovirus p17 through the activation of p53 pathway. Biochem. Biophys. Res. Commun. 2005, 336, 709–715. [Google Scholar] [CrossRef] [PubMed]
- Chi, P.I.; Huang, W.R.; Lai, I.H.; Cheng, C.Y.; Liu, H.J. The p17 nonstructural protein of avian reovirus triggers autophagy enhancing virus replication via activation of PTEN and AMPK as well as PKR/eIF2α signaling pathways. J. Biol. Chem. 2013, 288, 3571–3584. [Google Scholar] [CrossRef]
- Chiu, H.C.; Huang, W.R.; Wang, Y.Y.; Li, J.Y.; Liao, T.L.; Nielsen, B.L.; Liu, H.J. Heterogeneous Nuclear Ribonucleoprotein A1 and Lamin A/C Modulate Nucleocytoplasmic Shuttling of Avian Reovirus p17. J. Virol. 2019, 93, e00851-19. [Google Scholar] [CrossRef] [PubMed]
- Chiu, H.C.; Huang, W.R.; Liao, T.L.; Chi, P.I.; Nielsen, B.L.; Liu, J.H.; Liu, H.J. Mechanistic insights into avian reovirus p17-modulated suppression of cell cycle CDK-cyclin complexes and enhancement of p53 and cyclin H interaction. J. Biol. Chem. 2018, 293, 12542–12562. [Google Scholar] [CrossRef] [PubMed]
- Ding, L.; Cao, J.; Lin, W.; Chen, H.; Xiong, X.; Ao, H.; Yu, M.; Lin, J.; Cui, Q. The Roles of Cyclin-Dependent Kinases in Cell-Cycle Progression and Therapeutic Strategies in Human Breast Cancer. Int. J. Mol. Sci. 2020, 21, 1960. [Google Scholar] [CrossRef] [PubMed]
- Chiu, H.C.; Huang, W.R.; Liao, T.L.; Wu, H.Y.; Munir, M.; Shih, W.L.; Liu, H.J. Suppression of Vimentin Phosphorylation by the Avian Reovirus p17 through Inhibition of CDK1 and Plk1 Impacting the G2/M Phase of the Cell Cycle. PLoS ONE 2016, 11, e0162356. [Google Scholar] [CrossRef]
- Huang, W.R.; Chiu, H.C.; Liao, T.L.; Chuang, K.P.; Shih, W.L.; Liu, H.J. Avian Reovirus Protein p17 Functions as a Nucleoporin Tpr Suppressor Leading to Activation of p53, p21 and PTEN and Inactivation of PI3K/AKT/mTOR and ERK Signaling Pathways. PLoS ONE 2015, 10, e0133699. [Google Scholar] [CrossRef] [PubMed]
- Manocha, E.; Bugatti, A.; Belleri, M.; Zani, A.; Marsico, S.; Caccuri, F.; Presta, M.; Caruso, A. Avian Reovirus P17 Suppresses Angiogenesis by Promoting DPP4 Secretion. Cells 2021, 10, 259. [Google Scholar] [CrossRef] [PubMed]
- Zhang, C.; He, L.; Kang, K.; Chen, H.; Xu, L.; Zhang, Y. Screening of cellular proteins that interact with the classical swine fever virus non-structural protein 5A by yeast two-hybrid analysis. J. Biosci. 2014, 39, 63–74. [Google Scholar] [CrossRef]
- Jamialahmadi, O.; Motamedian, E.; Hashemi-Najafabadi, S. BiKEGG: A COBRA toolbox extension for bridging the BiGG and KEGG databases. Mol. Biosyst. 2016, 12, 3459–3466. [Google Scholar] [CrossRef] [PubMed]
- Szklarczyk, D.; Gable, A.L.; Nastou, K.C.; Lyon, D.; Kirsch, R.; Pyysalo, S.; Doncheva, N.T.; Legeay, M.; Fang, T.; Bork, P.; et al. Correction to 'The STRING database in 2021: Customizable protein-protein networks, and functional characterization of user-uploaded gene/measurement sets. Nucleic Acids Res. 2021, 49, 10800. [Google Scholar] [CrossRef]
- Jiang, Z.; Wei, F.; Zhang, Y.; Wang, T.; Gao, W.; Yu, S.; Sun, H.; Pu, J.; Sun, Y.; Wang, M.; et al. IFI16 directly senses viral RNA and enhances RIG-I transcription and activation to restrict influenza virus infection. Nat. Microbiol. 2021, 6, 932–945. [Google Scholar] [CrossRef]
- Ka, N.L.; Lim, G.Y.; Hwang, S.; Kim, S.S.; Lee, M.O. IFI16 inhibits DNA repair that potentiates type-I interferon-induced antitumor effects in triple negative breast cancer. Cell Rep. 2021, 37, 110138. [Google Scholar] [CrossRef] [PubMed]
- Johnson, K.E.; Bottero, V.; Flaherty, S.; Dutta, S.; Singh, V.V.; Chandran, B. Correction: IFI16 Restricts HSV-1 Replication by Accumulating on the HSV-1 Genome, Repressing HSV-1 Gene Expression, and Directly or Indirectly Modulating Histone Modifications. PLoS Pathog. 2018, 14, e1007113. [Google Scholar] [CrossRef]
- Jimenez, A.; Santos, M.A.; Revuelta, J.L. Phosphoribosyl pyrophosphate synthetase activity affects growth and riboflavin production in Ashbya gossypii. BMC Biotechnol. 2008, 8, 67. [Google Scholar] [CrossRef]
- Li, L.; Pang, X.; Zhu, Z.; Lu, L.; Yang, J.; Cao, J.; Fei, S. GTPBP4 Promotes Gastric Cancer Progression via Regulating P53 Activity. Cell. Physiol. Biochem. 2018, 45, 667–676. [Google Scholar] [CrossRef] [PubMed]
- Rahman, S.K.; Okazawa, H.; Chen, Y.W. Frameshift PQBP-1 mutants K192S(fs*7) and R153S(fs*41) implicated in X-linked intellectual disability form stable dimers. J. Struct. Biol. 2019, 206, 305–313. [Google Scholar] [CrossRef] [PubMed]
- Zhang, X.; Yao, Y.; Han, J.; Yang, Y.; Chen, Y.; Tang, Z.; Gao, F. Longitudinal epitranscriptome profiling reveals the crucial role of N(6)-methyladenosine methylation in porcine prenatal skeletal muscle development. J. Genet. Genom. 2020, 47, 466–476. [Google Scholar] [CrossRef] [PubMed]
- Bhushan, B.; Apte, U. Liver Regeneration after Acetaminophen Hepatotoxicity: Mechanisms and Therapeutic Opportunities. Am. J. Pathol. 2019, 189, 719–729. [Google Scholar] [CrossRef] [PubMed]
- Ramaswamy, G.; Sohn, P.; Eberhardt, A.; Serra, R. Altered responsiveness to TGF-beta results in reduced Papss2 expression and alterations in the biomechanical properties of mouse articular cartilage. Arthritis Res. Ther. 2012, 14, R49. [Google Scholar] [CrossRef] [PubMed]
- Tsai, T.Y.; Sikora, M.; Xia, P.; Colak-Champollion, T.; Knaut, H.; Heisenberg, C.P.; Megason, S.G. An adhesion code ensures robust pattern formation during tissue morphogenesis. Science 2020, 370, 113–116. [Google Scholar] [CrossRef]
- Zhou, L.; Li, J.; Haiyilati, A.; Li, X.; Gao, L.; Cao, H.; Wang, Y.; Zheng, S.J. Gga-miR-29a-3p suppresses avian reovirus-induced apoptosis and viral replication via targeting Caspase-3. Vet. Microbiol. 2022, 264, 109294. [Google Scholar] [CrossRef] [PubMed]
- Xie, L.; Wang, S.; Xie, Z.; Wang, X.; Wan, L.; Deng, X.; Xie, Z.; Luo, S.; Zeng, T.; Zhang, M.; et al. Gallus NME/NM23 nucleoside diphosphate kinase 2 interacts with viral sigmaA and affects the replication of avian reovirus. Vet. Microbiol. 2021, 252, 108926. [Google Scholar] [CrossRef] [PubMed]

| Gene Name | Primer Sequence (5’-3’) | Note | Accession Number |
|---|---|---|---|
| AD-F AD-R | TAATACGACTCACTATAGGGCT GTGAACTTGCGGGGTTTTTCAGTATCTACGATT | Amplification of cDNA inserted in AD plasmid | |
| p17-GFP-F | GCGAATTCTATGCAATGGCTCCGCCATACG | Amplification of ARV p17 gene with GFP label | |
| p17-GFP-R | GCGGATCCCTCATGGATCGGCGTCAAATCG | ||
| p17-Flag-F | ATTGGATCCTATGCAATGGCTCCGCCATACG | Amplification of ARV p17 gene with Flag tag Amplification of ARV p17 gene with GST label | |
| p17-Flag-R p17-GST-F p17-GST-R | ATTCTCGAGTCACTTATCGTCGTCATCCTTGTAATCCTCATGGATCGGCGTCAAATCG GCGAATTCTATGCAATGGCTCCGCCATACG GCCTCGAGCTCATGGATCGGCGTCAAATCG | ||
| PQBP1-RED-F | CGGAATTCATATGCCGCTGCCCGTTG | Amplification of PQPB1 gene with RED label Amplification of PQBP1 gene with Myc tag | AJ973596.1 |
| PQBP1-RED-R PQBP1-Myc-F PQBP1-Myc-R | CGGGATCCACCTGCTGCTTGGTT ATTGGATCCATGCCGCTGCCCGTTG ATTCTCGAGTCACAGATCCTCTTCAGAGATGAGTTTCTGCTCACCTGCTGCTTGGTT | ||
| IGF2BP1-RED-F | CGGAATTCCCGTTGCTGTCGGG | Amplification of IGF2BP1 gene with RED label Amplification of IGF2BP1 gene with Myc tag Amplification of FGF1 gene with RED label Amplification of FGF1 gene with Myc tag | NM_205071.1 |
| IGF2BP1-RED-R IGF2BP1-Myc-F IGF2BP1-Myc-R FGF1-RED-F FGF1-RED-F FGF1-Myc-F FGF1-Myc-R | CGGGATCCGTTCTTAGCCCCAT ATTGGATCCATGCCGTTGCTGTCGGG ATTCTCGAGTCACAGATCCTCTTCAGAGATGAGTTTCTGCTCGTTCTTAGCCCCAT CGGAATTCATGGCCGAGGGGG CGGGATCCGGCACGCTTGGATC ATTGGATCCATGGCCGAGGGGG ATTCTCGAGTCACAGATCCTCTTCAGAGATGAGTTTCTGCTCGGCACGCTTGGATC | KY747397 | |
| IGF2BP1-F | AAGGCACAAGGCAGGATT | Detect the expression of IGF2BP1 by RT qPCR | NM_205071.1 |
| IGF2BP1-R | GCAGCTCATTGACGGTTTT | ||
| FGF1-F | AAAAGCACGCAGACAAGAAC | Detect the expression of FGF1 by RT qPCR | KY747397 |
| FGF1-R | CATTGGAACACCAGGAAGG | ||
| PAPSS2-F | TTGATGCAGGACACTCGC | Detect the expression of PAPSS2 by RT qPCR | XM_040674794 |
| PAPSS2-R | CAATGGTTGACTTGGGAT | ||
| RPL5-F RPL5-R | TTTCCCTGGTTATGACTC AGCATCTTCATCCTCCTC | Detect the expression of RPL5 by RT qPCR | XM_031614822.1 |
| DHRS3-F DHRS3-R | ATGCCTGTTGAGGTCTGC AAAGTTTGGTGGAGTGGA | Detect the expression of DHRS3 by RT qPCR | NM_001277910.3 |
| NEDD4L-F NEDD4L-R | TGCGGATAGCACCCAATG TCCTTTCCTCCCAACCAG | Detect the expression of NEDD4L by RT qPCR | XM_031609223.1 |
| CDH2-F CDH2-R | ATCCTACTGGACGGTTCG TTGGCTAATGGCACTTGA | Detect the expression of CDH2 by RT qPCR | NM_001001615 |
| PRPS2-F PRPS2-R | CGTGGAGCGTTGGAGTCGT GCGGGTTCTGCATACAGGTTAT | Detect the expression of PRPS2 by RT qPCR | NM_001006264.1 |
| PQBP1-F PQBP1-R IFI16-F IFI16-R | TGCCGAGGACTATGACGA AGCTTCTTGGCCGATTTG CTGGAACGAAAGGGAG TTGGGTGGAGCTGAT | Detect the expression of PQBP1 by RT qPCR Detect the expression of IFI16 by RT qPCR | AJ973596.1 NM_001131692.1 |
| ARV-F ARV-R | CGTATCATTCACCCGCGATT TGTTCGCTGTACCATCACCT | Detect the replicaiton of ARV by RT qPCR | |
| GAPDH-F GAPDH-R Si-PQBP1 Si-IGF2BP1 Si-FGF1 Si-Negative | GGTGGTGCTAAGCGTGTTA CCCTCCACAATGCCAA UGGCCAAGAGAGGCAUCCUCAAACA CAGUGGGCCAUGAAAGCCAUCGAAA CGGAAGAUGUGGGCGAGGUCUAUAU UUCUCCGAACGUGUCACGUUU | Detect the expression of GAPDH by RT qPCR SiRNA target of PQBP1 SiRNA target of IGF2BP1 SiRNA target of FGF1 Negative control | AJ973596.1 NM_205071.1 KY747397 |
| No. | GenBank | Protein Name | Description | ORF (bp) |
|---|---|---|---|---|
| 1 | NM_001006264.1 | Ribose-phosphate pyrophosphokinase 2 (PRPS2) | Activated by magnesium and inorganic phosphate. Competitively or non-competitively inhibited by ADP, or GDP. | 1231 |
| 2 | NM_001131692.1 | Gamma-interferon-inducible protein 16 (IFI16) | A predominantly nuclear protein involved in transcriptional regulation, also functions as an innate immune response DNA sensor and induces the IL-1β and antiviral type-1 interferon-β (IFN-β) cytokines. | 3012 |
| 3 | NM_001006354.1 | Nucleolar GTP-binding protein 1 (GTPBP4) | Nucleolar GTP-binding protein 1 is a protein that in humans is encoded by the GTPBP4 gene. | 1983 |
| 4 | AJ973596.1 | Polyglutamine-binding protein 1 (PQBP1) | A protein predominantly expressed in lymphoid and myeloid cells was initially identified in the pre-mRNA splicing by interacting with splicing-related factors. | 1133 |
| 5 | NM_205071.1 | Insulin-like growth factor 2 mRNA-binding protein 1 (IGF2BP1) | It serves as a post-transcriptional fine-tuner regulating the expression of some essential mRNA targets required for the control of tumor cell proliferation and growth, invasion, and chemo-resistance, and metastasis in various types of human cancers. | 2021 |
| 6 | XM_040679547 | Neutral cholesterol ester hydrolase 1 (NCEH1) | Hydrolysis of intracellular CE is the rate-limiting step in the cholesterol efflux from macrophage foam cells. As the hydrolysis of CE takes place at neutral pH, the enzymes catalyzing it have been collectively called neutral CE hydrolases (NCEHs). | 5520 |
| 7 | KY747397 | Fibroblast growth factor (FGF1) | Fibroblast growth factors (FGFs) that signal through FGF receptors (FGFRs) regulate a broad spectrum of biological functions, including cellular proliferation, survival, migration, and differentiation. | 556 |
| 8 | XM_040674794 | 3'-phosphoadenosine-5'-phosphosulfate synthase (PAPSS2) | Blood clotting, bone development 3'-Adenosine phosphate-5'-Sulphate biosynthesis | 6730 |
| 9 | NM_001001615 | Cadherin-2 (CDH2) | This protein plays a role in the establishment of left-right asymmetry, development of the nervous system and the formation of cartilage and bone. | 3203 |
| 10 | XM_031614822.1 | Phasianus colchicus ribosomal protein L5 (RPL5) | The encoded protein binds 5S rRNA to form a stable complex called the 5S ribonucleoprotein particle (RNP), which is necessary for the transport of non-ribosome-associated cytoplasmic 5S rRNA to the nucleolus for assembly into ribosomes. | 1034 |
| 11 | XM_015855784.2 | Coturnix japonica ribosomal protein L7 (RPL7) | The protein has been shown to be an autoantigen in patients with systemic autoimmune diseases. As is typical for genes encoding ribosomal proteins, there are multiple processed pseudogenes of this gene dispersed through the genome. | 921 |
| 12 | XM_025153616.1 | Gallus gallus discs large MAGUK scaffold protein 1 (DLG1) | This gene encodes a multi-domain scaffolding protein that is required for normal development. This protein may have a role in septate junction formation, signal transduction, cell proliferation, synaptogenesis and lymphocyte activation. | 4586 |
| 13 | NM_001277910.3 | Gallus gallus dehydrogenase/reductase 3 (DHRS3) | DHRS3 (dehydrogenase/reductase 3) is a protein coding gene. Diseases associated with DHRS3 include amphetamine abuse and neuroblastoma. Among its related pathways are vitamin A and carotenoid metabolism and metabolism of fat-soluble vitamins. | 4798 |
| 14 | XM_031609223.1 | Phasianus colchicus NEDD4 like E3 ubiquitin protein ligase (NEDD4L) | NEDD4Lis a protein coding gene. Diseases associated with NEDD4L include periventricular nodular heterotopia 7 and periventricular nodular heterotopia. | 7445 |
| 15 | XM_040694238.1 | Gallus gallus FERM domain containing 8 (FRMD8) | It has confirmed the pathophysiological significance of FRMD8 in iPSC-derived human macrophages and mouse tissues, thus demonstrating its role in the regulated release of multiple cytokine and growth factor signals. | 9815 |
| 16 | XM_015294442 | Gallus gallus zinc finger protein 598 (ZNF598) | It plays an important role in regulating gene expression, cell differentiation, embryo development and other life processes. | 2797 |
| 17 | AJ720578.1 | Gallus gallus mRNA for hypothetical protein | Hypothetical protein | 838 |
| 18 | XR_004306526.1 | Coturnix japonica uncharacterized LOC116653138 | Predicted protein | 2760 |
| 19 | XM_025145628.1 | Gallus gallus NADH-ubiquinone oxidoreductase chain 1-like LOC112530942 | Predicted protein | 1821 |
Publisher’s Note: MDPI stays neutral with regard to jurisdictional claims in published maps and institutional affiliations. |
© 2022 by the authors. Licensee MDPI, Basel, Switzerland. This article is an open access article distributed under the terms and conditions of the Creative Commons Attribution (CC BY) license (https://creativecommons.org/licenses/by/4.0/).
Share and Cite
Zhang, C.; Liu, X.; Zhao, F.; Zhang, Q.; Zuo, W.; Guo, M.; Zhang, X.; Wu, Y. Identification and Functional Analyses of Host Proteins Interacting with the p17 Protein of Avian Reovirus. Viruses 2022, 14, 892. https://doi.org/10.3390/v14050892
Zhang C, Liu X, Zhao F, Zhang Q, Zuo W, Guo M, Zhang X, Wu Y. Identification and Functional Analyses of Host Proteins Interacting with the p17 Protein of Avian Reovirus. Viruses. 2022; 14(5):892. https://doi.org/10.3390/v14050892
Chicago/Turabian StyleZhang, Chengcheng, Xinyi Liu, Fuxi Zhao, Qingqing Zhang, Wei Zuo, Mengjiao Guo, Xiaorong Zhang, and Yantao Wu. 2022. "Identification and Functional Analyses of Host Proteins Interacting with the p17 Protein of Avian Reovirus" Viruses 14, no. 5: 892. https://doi.org/10.3390/v14050892
APA StyleZhang, C., Liu, X., Zhao, F., Zhang, Q., Zuo, W., Guo, M., Zhang, X., & Wu, Y. (2022). Identification and Functional Analyses of Host Proteins Interacting with the p17 Protein of Avian Reovirus. Viruses, 14(5), 892. https://doi.org/10.3390/v14050892

